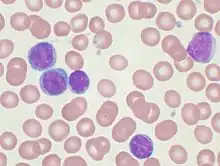

Chronic lymphocytic leukemia
| Chronic lymphocytic leukemia | |
|---|---|
| Other names | B-cell chronic lymphocytic leukemia (B-CLL)[1] |
![]() | |
| Peripheral blood smear showing CLL cells | |
| Specialty | Hematology and oncology |
| Symptoms | Early: None[2] Later: Non-painful lymph nodes swelling, feeling tired, fever, weight loss, night sweats[2] |
| Usual onset | Older than 50[3] |
| Risk factors | Family history, tobacco use, Agent Orange, certain insecticides[2][4] |
| Diagnostic method | Blood tests[5] |
| Differential diagnosis | Mononucleosis, hairy cell leukemia, acute lymphocytic leukemia, persistent polyclonal B-cell lymphocytosis[5] |
| Treatment | Watchful waiting, chemotherapy, immunotherapy[4][5] |
| Prognosis | Five-year survival ~88% (US)[3] |
| Frequency | 904,000 (2015)[6] |
| Deaths | 60,700 (2015)[7] |
Chronic lymphocytic leukemia (CLL) is a type of cancer that affects the blood and bone marrow.[8][9] In CLL, the bone marrow makes too many lymphocytes, which are a type of white blood cell.[8][9] In patients with CLL, B cell lymphocytes can begin to collect in their blood, spleen, lymph nodes, and bone marrow.[10][4] These cells do not function well and crowd out healthy blood cells.[2] CLL is divided into two main types:
- Slow-growing CLL (indolent CLL)
- Fast-growing CLL[11]
Many people do not have any symptoms when they are first diagnosed.[8][2] Those with symptoms (about 5-10% of patients with CLL) may experience the following:
- Fevers
- Fatigue
- Night sweats
- Unexplained weight loss
- Loss of appetite
- Painless lymph node swelling
- Enlargement of the spleen, and/or
- A low red blood cell count (anemia).[10][4][2][12]
These symptoms may worsen over time.[8][2]
While the exact cause of CLL is unknown, having a family member with CLL increases one's risk of developing the disease.[10][4] Environmental risk factors include exposure to Agent Orange, ionizing radiation, and certain insecticides.[12][4] The use of tobacco is also associated with an increased risk of having CLL.[10]
Diagnosis is typically based on blood tests that find high numbers of mature lymphocytes and smudge cells.[5]

When patients with CLL are not experiencing symptoms (i.e. are asymptomatic), they only need careful observation.[13] This is because there is currently no evidence that early intervention can alter the course of the disease.[13]
Patients with CLL have an increased risk of developing serious infections.[13] Thus, they should be routinely monitored and promptly treated with antibiotics if an infection is present.[13]
In patients with significant signs or symptoms, treat can involve chemotherapy, immunotherapy, or chemoimmunotherapy.[4] The most appropriate treatment is based on the individual's age, physical condition, and whether they have the del(17p) or TP53 mutation.[14]
As of 2024, the recommended first-line treatments include:
- Bruton tyrosine kinase inhibitors (BTKi), such as such as ibrutinib, zanubrutinib, and acalabrutinib
- B-cell lymphoma-2 (BCL-2) inhibitor, venetoclax, plus a CD20 antibody obinutuzumab, OR
- BTKi (i.e. ibrutinib) plus BCL-2 inhibitor (i.e. venetoclax)[15][16][17]
CLL is the most common type of leukemia in the Western world. It most commonly affects individuals over the age of 65, due to the accumulation of genetic mutations that occur over time.[3][18] CLL is rarely seen in individuals less than 40 years old.[19] Men are more commonly affected than women, although the average lifetime risk for both genders are similar (around 0.5-1%) .[19][20] It represents less than 1% of deaths from cancer.[7]
Signs and symptoms
Most people are diagnosed as having CLL based on the result of a routine blood test that shows a high white blood cell count, specifically a large increase in the number of circulating lymphocytes.[12] Most commonly, patients have no symptoms at first.[12] In a small number of cases, patients with CLL may present with enlarged lymph nodes, partially in areas around the neck, armpit, or groin.[12] In rare circumstances, the disease is recognized only after the cancerous cells overwhelm the bone marrow, resulting in low red blood cells, neutrophils, or platelets.[12] This can then result in symptoms such as fever, easy bleeding/bruising, night sweats, weight loss, and increased tiredness.[12] In some instances, the cancerous cells can accumulate in the spleen and result in splenomegaly.[10]
Complications
About 25% of patients with CLL have very low levels of antibodies in their bloodstream (hypogammaglobulinemia) at diagnosis, with several more patients developing this throughout the course of their disease.[21] This decrease in antibodies increases the patient's risk of recurrent infections and other autoimmune complications, such as autoimmune hemolytic anemia and immune thrombocytopenia.[21] Autoimmune hemolytic anemia occurs in about 5-10% of CLL patients, which is when one's own immune system attacks its own red blood cells.[21]
A more serious complication called Richter's transformation (RT) occurs in 2-10% of patients with CLL.[22] This is a process in which the original CLL cells convert to a far more aggressive disease that has the biology and histopathology of diffuse large B cell lymphoma or less commonly Hodgkin's lymphoma.[23][22] These patients typically present with a sudden clinical deterioration that can be characterized by unexplained fevers or weight loss, asymmetric and rapid growth of lymph nodes, and/or a significant drop in the number of white blood cells, red blood cells, or platelets.[22] Treatment for RT typically consists of various chemotherapy/chemo-immunotherapy protocols.[22]
CLL has also been reported to convert into other more aggressive diseases such as lymphoblastic lymphoma, hairy cell leukemia, high grade T cell lymphomas,[24] acute myeloid leukemia,[25] lung cancer, brain cancer, melanoma of the eye or skin,[26][27] salivary gland tumors, and Kaposi's sarcomas.[28] While some of these conversions have been termed RTs, the World Health Organization[29] and most reviews[23] have defined RT as a conversion of CLL/SLL into a disease with DLBCL or HL histopathology.[30]
Gastrointestinal (GI) involvement can also rarely occur with chronic lymphocytic leukemia.[21] Some of the reported manifestations include intussusception, small intestinal bacterial contamination, colitis, and bleeding.[21] Usually, GI complications with CLL occur after Richter transformation. Two cases to date have been reported of GI involvement in chronic lymphocytic leukemia without Richter's transformation.[31]
Causes
The exact cause of CLL is unknown. However, family history has been strongly correlated with the development of disease.[10] Environmental factors may also play a role in the development of CLL.[10] For instance, exposure to Agent Orange increases the risk of CLL, and exposure to hepatitis C virus may increase the risk.[32] There is no clear association between ionizing radiation exposure and the risk of developing CLL.[32] Blood transfusions have been ruled out as a risk factor.[4]
Mechanism

CLL results from an unusual growth and expansion of white blood cells. This manifestation typically begins with a single hematopoietic stem cell that acquires certain mutations over time that allows it to continue to expand and grow at a faster rate than other cells.[33] Each patient with CLL may be affected by a different set of mutations, making these cells sometimes difficult to target and treat. Some of the most common mutations that have been found in CLL-affected cells include the following: NOTCH1, TP53, ATM, and SF3B1.[33]
CLL can also be caused by a number of epigenetic changes, which are adaptations that add a tag to specific DNA sequences, rather than altering the sequence itself. In CLL, these changes can be classified into the addition of three different methyl subgroups (naïve B-cell-like, memory B-cell-like, and intermediate), which impact how much that DNA sequence is transcribed.[34][35] Some relevant genetic mutations may be inherited. Since there is no one single mutation that is associated with CLL in all cases, an individual's susceptibility may be impacted when multiple mutations that are associated with an increase in the risk of CLL are co-inherited.[36] Up until 2020, 45 susceptibility loci have been identified. Of these loci, 93% are linked to the alteration of 30 gene expressions involved in immune response, cell survival, or Wnt signaling.[33]
As CLL cells accumulate, they begin to promote inflammation and an immunosuppressive environment through the release of different chemical signals.[33]
CLL is commonly preceded by a pre-cancerous state known as monoclonal B-cell lymphocytosis (MBL).[33] This occurs when there is in an increase in a specific type of white blood cells but the number remains less than 5 billion cells per liter (L) (5x109/L) of blood.[33] This subtype, termed chronic lymphocytic leukemia-type MBL (CLL-type MBL) is an asymptomatic, indolent, and chronic disorder in which people exhibit a mild increase in the number of circulating B-cell lymphocytes. These B-cells are monoclonal, which means they are produced by a single ancestral B-cell. They share some of the same cell marker proteins, chromosome abnormalities, and gene mutations that are found in CLL.[37][38]
CLL-type MBL can be separated into two groups:
- Low-count MBL has monoclonal B-cell blood counts of <0.5x109 cells/liter (i.e. 0.5x109/L)
- High-count MBL has blood monoclonal B-cell counts ≥0.5x109/L but <5x109/L.[39]
Low-count MBL rarely if ever progresses to CLL, while high-count CLL/SLL MBL does so at a rate of around 1% per year.[33] Thus, CLL may present in individuals with a long history of having high-count MBL. There is no established treatment for these individuals except monitoring for development of the disorder's various complications (see treatment of MBL complications) and for their progression to CLL.[40][41]
Diagnosis

The diagnosis of CLL is based on the demonstration of an abnormal population of B lymphocytes in the blood, bone marrow, or tissues that display an unusual but characteristic pattern of molecules on the cell surface. CLL is usually first suspected by a diagnosis of lymphocytosis, an increase in a type of white blood cell, on a complete blood count test. This frequently is an incidental finding on a routine physician visit. Most often the lymphocyte count is greater than 5000 cells per microliter (μL) of blood but can be much higher.[41] The presence of lymphocytosis in a person who is elderly should raise strong suspicion for CLL, and a confirmatory diagnostic test, in particular flow cytometry should be performed unless clinically unnecessary.[42]
Classification
In order to be diagnosed with CLL, the patient must have a white blood cell count greater than 5 billion cells per liter (L) (5x109/L) of blood. If CLL-type cells are mainly found in the lymph nodes or lymphoid tissue (such as the spleen), a diagnosis of small lymphocytic lymphoma (SLL) is made.[43] However, when these cancerous cells appear mostly in the blood, the disease is classified as CLL.[43][44]
Clinical staging
Staging, which helps determine the extent of the disease, is done using one of two systems: the Rai staging system or the Binet classification.[2][45] These systems are simple, requiring the use of only physical examination and blood test results.[45]
Rai staging system[45] (most commonly used in the United States) [46]
- Low-risk disease (formerly Stage 0): characterized by lymphocytosis with cancer cells in the blood and/or bone marrow without lymphadenopathy, hepatosplenomegaly, anemia, or thrombocytopenia
- Intermediate-risk disease (formerly Stage I/II): characterized by lymphocytosis, swollen lymph nodes (may be palpable or not), spleen enlargement, and/or liver enlargement
- High-risk disease (formerly Stage III/IV): characterized by lymphocytosis with associated anemia (hemoglobin <11 g/dL) OR thrombocytopenia (<100,000/mm3) with or without lymphadenopathy, hepatomegaly, splenomegaly, or anemia
Binet classification[47] (most commonly used in Europe):[46] This classification system is based on the number of areas within the body that have been affected and the presence of anemia or thrombocytopenia.[45] Areas of involvement include the (1) head and neck (considered one), (2) one or both of the armpits, (3) the groin, (4) the spleen, and (5) the liver.[45] They are considered affected if a lymph node greater than 1 cm in diameter is present and/or the spleen or liver are palpable.[45]
- Clinical stage A: characterized by no anemia (Hb > 10 g/dL) or thrombocytopenia (platelets > 100 x 109/L) and no greater than two areas of lymphoid involvement (described above)
- Clinical stage B: characterized by no anemia (Hb > 10 g/dL) or thrombocytopenia (platelets > 100 x 109/L) with three or more areas of lymphoid involvement
- Clinical stage C: characterized by anemia (Hb < 10 g/dL) and/or thrombocytopenia (platelets < 100 x 109/L) regardless of the number of areas of lymph node or organ enlargement
Array-based karyotyping
Array-based karyotyping is a cost-effective alternative to FISH for detecting chromosomal abnormalities in CLL. Several clinical validation studies have shown >95% concordance with the standard CLL FISH panel.[48][49][50][51][52]
Molecular examination of peripheral blood and flow cytometry
The combination of the microscopic examination of the peripheral blood and analysis of the lymphocytes by flow cytometry to confirm clonality and molecular expression is needed to establish the diagnosis of CLL.[53] Both are easily accomplished with a small sample of blood.
A flow cytometer instrument can examine the expression of molecules on individual cells. This requires the use of specific antibodies to cell-surface molecules that have fluorescent tags that are recognized by the instrument.[54] In CLL, the lymphocytes are all genetically identical since they are derived from the same B cell lineage. CLL cells can express the typical B-cell markers such as CD19 and CD20, as well as abnormal surface markers such as CD5 and CD23.[32]
On a peripheral blood smear, CLL cells resemble normal lymphocytes, although slightly smaller. They are also very fragile and susceptible to breaking when smeared onto a glass slide, giving rise to "smudge" or "smear" cells, which are a hallmark of the disease.[53][55] Smudge cells are a result of CLL cells lacking vimentin, a type of cytoskeleton proteins which is a structural component in a cell which maintains the cell's internal shape and mechanical resilience).[56]: 1899 [57]

Surface markers
The atypical molecular pattern on the surface of the cell includes the co-expression of cell surface markers clusters of differentiation 5 (CD5) and 23. In addition, all the CLL cells within one individual are clonal, that is, genetically identical. In practice, this is inferred by the detection of only one of the mutually exclusive antibody light chains, kappa or lambda, on the entire population of the abnormal B cells. Normal B lymphocytes consist of a stew of different antibody-producing cells, resulting in a mixture of both kappa- and lambda-expressing cells. The lack of the normal distribution of these B cells is one basis for demonstrating clonality, the key element for establishing a diagnosis of any B cell malignancy (B cell non-Hodgkin lymphoma).[58] The Matutes's CLL score allows the identification of a homogeneous subgroup of classical CLL, that differs from atypical/mixed CLL for the five markers' expression (CD5, CD23, FMC7, CD22, and immunoglobulin light chain) Matutes's CLL scoring system is very helpful for the differential diagnosis between classical CLL and the other B cell chronic lymphoproliferative disorders, but not for the immunological distinction between mixed/atypical CLL and mantle cell lymphoma (MCL malignant B cells).[59] Discrimination between CLL and MCL can be improved by adding non-routine markers such as CD54[60] and CD200.[61] Among routine markers, the most discriminating feature is the CD20/CD23 mean fluorescence intensity ratio. In contrast, FMC7 expression can surprisingly be misleading for borderline cases.[62]
Related diseases
In the past, cases with similar microscopic appearance in the blood but with a T cell phenotype were referred to as T-cell CLL. However, these are now recognized as a separate disease group and are currently classified as T-cell prolymphocytic leukemias (T-PLL).[63][64] An accurate diagnosis of T-PLL is important as it is a rare and aggressive disease.[65]
CLL should not be confused with acute lymphoblastic leukemia, a highly aggressive leukemia most commonly diagnosed in children, and highly treatable in the pediatric setting.
Differential diagnosis
| Lymphoid disorders that can present as chronic leukemia and can be confused with typical B-cell chronic lymphoid leukemia[66] |
|---|
| Follicular lymphoma |
| Splenic marginal zone lymphoma |
| Nodal marginal zone B cell lymphoma |
| Mantle cell lymphoma |
| Hairy cell leukemia |
| Prolymphocytic leukemia (B cell or T cell) |
| Lymphoplasmacytic lymphoma |
| Sézary syndrome |
| Smoldering adult T cell leukemia/lymphoma |
Hematologic disorders that may resemble CLL in their clinical presentation, behavior, and microscopic appearance include mantle cell lymphoma, marginal zone lymphoma, B cell prolymphocytic leukemia, and lymphoplasmacytic lymphoma.
- B cell prolymphocytic leukemia, a related, but more aggressive disorder, has cells with similar phenotype, but are significantly larger than normal lymphocytes and have a prominent nucleolus. The distinction is important as the prognosis and therapy differ from CLL.[67]
- Hairy cell leukemia is also a neoplasm of B lymphocytes, but the neoplastic cells have a distinct morphology under the microscope (hairy cell leukemia cells have delicate, hair-like projections on their surfaces) and unique marker molecule expression.[68]
All the B cell malignancies of the blood and bone marrow can be differentiated from one another by the combination of cellular microscopic morphology, marker molecule expression, and specific tumor-associated gene defects. This is best accomplished by evaluation of the patient's blood, bone marrow, and occasionally lymph node cells by a pathologist with specific training in blood disorders. A flow cytometer is necessary for cell marker analysis, and the detection of genetic problems in the cells may require visualizing the DNA changes with fluorescent probes by FISH.[69]
Prevention/Screening
Routine visits with your primary health care provider is recommended, so that they may regularly monitor your white blood cell count and watch out for the development of any signs or symptoms related to CLL.
Treatment
CLL treatment focuses on controlling and limiting the progress of the disease and its symptoms, as it currently remains incurable. In patients with little to no symptoms, watchful waiting with close observation is generally appropriate.[2]
Treatment is recommended when patients become symptomatic or experience one of the following:
- Dangerous drops in their red blood cell or platelet count
- A doubling of their white blood cells in 6 months or less
- Significant splenomegaly
- Severe swelling of the lymph nodes, and/or
- Richter transformation[16]
As of 2024, first-line treatment for CLL involves the use of targeted biological therapy.[16] Other treatment options include: chemotherapy, radiation therapy, bone marrow transplantation, and supportive or palliative care.[16]
Radiation therapy is usually only done in patients with SLL who have symptomatic localized disease, such as bulky lymph nodes.[70] In special circumstances, patients can develop massive splenomegaly that may lead to the destruction of red blood cells, white blood cells, and platelets.[70] In these cases, the patient may be treated with steroids or IVIG; however, if the patient does not respond to these treatments, they may have to undergo a splenectomy, removal of the spleen.[70]
CLL treatment regimens vary depending on the patient's age, physical health, and progression of their disease. There are several agents that may be used for the treatment of CLL.[2]
Decision to treat
While it is generally considered incurable, CLL progresses slowly in most cases. Many people with CLL lead normal and active lives for many years—in some cases for decades. Because of its slow onset, asymptomatic early-stage CLL (Rai 0, Binet A) is, in general, not treated since it is believed that early-stage CLL intervention does not improve survival time or quality of life. Instead, the condition is monitored over time to detect any change in the disease pattern.[2][71][72]
There are two widely used staging systems in CLL to determine when and how to treat the patient: The Rai staging system, used in the United States, and the Binet system in Europe. Both these systems attempt to characterize the disease based on the bulk and marrow failure.[2][46] A "watchful waiting" strategy is used for most patients with CLL.[46] The International Workshop on CLL (iwCLL) has issued guidelines with specific markers that should be met to initiate treatment, generally based on evidence for progressive symptomatic disease (summarized as "active disease").[72]
Targeted biological therapy
Targeted therapy attacks cancer cells at a specific target, with the aim of not harming normal cells. In patients will CLL, B-cell receptor (BCR) signaling appears to play a vital role in the growth and survival of CLL cells.[45] BCR signaling is supported by a number of different tyrosine kinase inhibitors (such as BTK, PI3K, etc.), which can all be targeted in order to help interfere with the growth of these CLL cells.[45] Another mechanism that CLL cells use to avoid destruction involves the use of proteins in the B-cell lymphoma (Bcl-2) family.[45] By blocking the function of those Bcl-2 proteins, targeted drugs can prevent further progression of CLL-related tumors.[45]
Some of the most common biological drugs used to treat CLL include:
- Bruton tyrosine kinase inhibitors (including ibrutinib, acalabrutinib, and zanubrutinib)
- BCL-2 inhibitors (including venetoclax), and
- Phosphatidylinositol 3-kinase inhibitors (including idelalisib and duvelisib).[2][73]
Monoclonal antibodies
Anti-CD20 antibodies
CD20 is a protein that is found on the surface of B-cells and thus serves as an important target in the treatment of many B-cell malignances, including CLL.[45] Some CD20 antibodies that have been used for the treatment of CLL include:[45]
- Rituximab
- Ofatumumab
- Obinutuzumab
These agents are usually used in refractory/relapsed disease or in combination with other agents, like chlorambucil (CLB), fludarabine, or venetoclax.[2][73][45]
Other monoclonal antibodies
- Alemtuzumab targets the CD52 receptor, which is usually found on the surface of many immune cells. This agent is also primarily used in refractory disease.[45]
Chemotherapy
Monotherapy using alkylating agents (i.e. chlorambucil and bendamustine) served as a front-line therapy for CLL for many years.[45] In fact, chlorambucil (CLB), was the "gold standard" treatment for CLL for several decades.[45] However, researchers found that it was not very effective at helping patients achieve remission; thus, it may not be used as frequently in practice anymore.[45]
Combination chemotherapy regimens can be effective in both newly diagnosed and relapsed CLL. Combinations of fludarabine with alkylating agents (cyclophosphamide) produce higher response rates and longer progression-free survival than single agents:
- FC (fludarabine with cyclophosphamide)[74][45]
- FR (fludarabine with rituximab)[75][45]
- FCR (fludarabine, cyclophosphamide, and rituximab)[76][45]
Although the purine analogue fludarabine was shown to give superior response rates to chlorambucil (CLB) as primary therapy, the early use of fludarabine has not been shown to improve overall survival, and some clinicians prefer to reserve fludarabine for relapsed disease.[77][78]
Chemoimmunotherapy with FCR has shown to improve response rates, progression-free survival, and overall survival in a large randomized trial in CLL patients selected for good physical fitness.[79]
Stem cell transplantation
Autologous stem cell transplantation, using the recipient's own cells, is not curative.[80] Younger individuals, if at high risk for dying from CLL, may consider allogeneic hematopoietic stem cell transplantation (HSCT). Myeloablative (bone marrow killing) forms of allogeneic stem cell transplantation, a high-risk treatment using blood cells from a healthy donor, may be curative, but treatment-related toxicity is significant.[80] An intermediate level, called reduced-intensity conditioning allogeneic stem cell transplantation, may be better tolerated by older or frail patients.[81][82]
Refractory CLL
"Refractory" CLL is a disease that no longer responds favorably to treatment within six months following the last cancer therapy.[72] In this case, more aggressive targeted therapies, such as BCR or BCL2 pathway inhibitors, have been associated with increased survival.[83]
Prognosis
Prognosis can be affected by the type of genetic mutation that the person with CLL has.[84] Some examples of genetic mutations and their prognoses are: mutations in the IGHV region are associated with a median overall survival (OS) of more than 20–25 years, while no mutations in this region is associated with a median OS of 8–10 years; deletion of chromosome 13q is associated with a median OS of 17 years; and trisomy of chromosome 12, as well as deletion of chromosome 11q, is associated with a median OS of 9–11 years.[2] While prognosis is highly variable and dependent on various factors including these mutations, the average 5-year relative survival is 86.1%.[85] Telomere length has been suggested to be a valuable prognostic indicator of survival.[86] In addition, a person's sex has been found to have an impact on CLL prognosis and treatment efficacy. More specifically, females have been found to survive longer (without disease progression) than males, when treated with certain medications.[87]
As of 2022, the most commonly used prognostic score is the CLL International Prognostic Index (CLL-IPI).[45] This system takes into account the following factors:[45]
- TP53 gene deletion and/or mutation
- Mutated immunoglobulin heavy chain variable (IGHV)
- Serum B2-microglobulin levels
- Clinical stage (see the Rai and Binet staging systems above)
- Age
Epidemiology
CLL is the most common type of leukemia in the Western world compared to non-Western regions such as Asia, Latin America, and Africa.[88] It is observed globally that males are twice as likely than females to acquire CLL.[88] CLL is primarily a disease of older adults, with 9 out of 10 cases occurring after the age of 50 years.[89] The median age of diagnosis is 70 years.[89] In young people, new cases of CLL are twice as likely to be diagnosed in men than in women.[90] In older people, however, this difference becomes less pronounced: after the age of 80 years, new cases of CLL are diagnosed equally between men and women.[90]
According to the American Cancer Society, they estimate that there will about 23,690 new cases of CLL with about 4,460 deaths from CLL in the United States throughout 2025.[19] Five-year survival following diagnosis is approximately 83% in the United States.[3] It represents less than 1% of deaths from cancer.[7]
Because of the prolonged survival, which was typically about 10 years in past decades, but which can extend to a normal life expectancy, the prevalence (number of people living with the disease) is much higher than the incidence (new diagnoses).[2] CLL is the most common type of leukemia in the UK, accounting for 38% of all leukemia cases. Approximately 3,200 people were diagnosed with the disease in 2011.[91]
In Western populations, subclinical "disease" can be identified in 3.5% of normal adults,[92] and in up to 8% of individuals over the age of 70.[93] That is, small clones of B cells with the characteristic CLL phenotype can be identified in many healthy elderly persons. The clinical significance of these cells is unknown.
In contrast, CLL is rare in Asian countries, such as Japan, China, and Korea, accounting for less than 10% of all leukemias in those regions.[80]: 1432 [94] A low incidence is seen in Japanese immigrants to the US, and in African and Asian immigrants to Israel.[80]
Of all cancers involving the same class of blood cell, 7% of cases are CLL/SLL.[95]
People who live near areas with considerable industrial pollution have an elevated risk of developing leukemia, particularly CLL.[96]
Research directions
In light of newer targeted therapies such as Bruton tyrosine kinase inhibitors and anti-CD20 monoclonal antibodies, the need for bone marrow transplants in patients with CLL has become rare.[97][98] Bone marrow transplants are only recommended in specific cases when front-line therapies have either failed and/or the patient continues to relapse.[99][45]
There have been major advances in the treatment of patients with CLL over the past 10 years or so.[17] Although this disease remains incurable, therapies such as Bruton tyrosine kinase inhibitors (including ibrutinib, acalabrutinib, and zanubrutinib), BCL-2 inhibitors (including venetoclax), and phosphatidylinositol 3-kinase inhibitors (including idelalisib and duvelisib) allow patients with CLL to now live longer.[17]
Despite the great success of these new targeted biological therapies so far, more research is needed in order to establish clearer guidelines on the optimal combination and sequence of these agents based on the patient's specific clinical presentation.[17][45] Furthermore, for patients who do not respond to these agents, treatment options are limited.[45] Thus, further research should be focused on discovering therapies that target other important chemical pathways.[45]
Special Populations
Pregnancy
Leukemia is rarely associated with pregnancy, affecting only about one in 10,000 pregnant women.[100] Treatment for chronic lymphocytic leukemias can often be postponed until after the end of the pregnancy. If treatment is necessary, then giving chemotherapy during the second or third trimesters is less likely to result in pregnancy loss or birth defects than treatment during the first trimester.[100]
See also
- Monoclonal B-cell lymphocytosis
- Virtual karyotype
- B-cell CLL/lymphoma
References
- ↑ O'Brien S, Gribben JG (2008). Chronic Lymphocytic Leukemia. CRC Press. p. 19. ISBN 9781420068962.
- 1 2 3 4 5 6 7 8 9 10 11 12 13 14 15 16 "Chronic Lymphocytic Leukemia Treatment". National Cancer Institute. 26 October 2017. Retrieved 19 December 2017.
- 1 2 3 4 "Chronic Lymphocytic Leukemia – Cancer Stat Facts". seer.cancer.gov. Retrieved 9 September 2022.
- 1 2 3 4 5 6 7 8 Kipps TJ, Stevenson FK, Wu CJ, Croce CM, Packham G, Wierda WG, et al. (January 2017). "Chronic lymphocytic leukaemia". Nature Reviews. Disease Primers. 3: 16096. doi:10.1038/nrdp.2016.96. PMC 5336551. PMID 28102226.
- 1 2 3 4 Ferri FF (2017). Ferri's Clinical Advisor 2018 E-Book: 5 Books in 1. Elsevier Health Sciences. p. 750. ISBN 9780323529570.
- ↑ Vos, Theo; et al. (October 2016). "Global, regional, and national incidence, prevalence, and years lived with disability for 310 diseases and injuries, 1990–2015: a systematic analysis for the Global Burden of Disease Study 2015". Lancet. 388 (10053): 1545–1602. doi:10.1016/S0140-6736(16)31678-6. PMC 5055577. PMID 27733282.
- 1 2 3 Wang, Haidong; et al. (October 2016). "Global, regional, and national life expectancy, all-cause mortality, and cause-specific mortality for 249 causes of death, 1980–2015: a systematic analysis for the Global Burden of Disease Study 2015". Lancet. 388 (10053): 1459–1544. doi:10.1016/s0140-6736(16)31012-1. PMC 5388903. PMID 27733281.
- 1 2 3 4 Shadman, Mazyar (2023-03-21). "Diagnosis and Treatment of Chronic Lymphocytic Leukemia: A Review". JAMA. 329 (11): 918–932. doi:10.1001/jama.2023.1946. ISSN 0098-7484. PMID 36943212.
- 1 2 "What Is Chronic Lymphocytic Leukemia?". www.cancer.org. Retrieved 2025-01-12.
- 1 2 3 4 5 6 7 Mukkamalla, Shiva Kumar R.; Taneja, Alankrita; Malipeddi, Dhatri; Master, Samip R. (2025), "Chronic Lymphocytic Leukemia", StatPearls, Treasure Island (FL): StatPearls Publishing, PMID 29261864, retrieved 2025-01-17
- ↑ "What Is Chronic Lymphocytic Leukemia?". www.cancer.org. Retrieved 2025-01-17.
- 1 2 3 4 5 6 7 Hallek M, Shanafelt TD, Eichhorst B (April 2018). "Chronic lymphocytic leukaemia". Lancet. 391 (10129): 1524–1537. doi:10.1016/S0140-6736(18)30422-7. PMID 29477250. S2CID 3517733.
- 1 2 3 4 Stilgenbauer S, Furman RR, Zent CS (2015-05-01). "Management of chronic lymphocytic leukemia". American Society of Clinical Oncology Educational Book. American Society of Clinical Oncology. Annual Meeting (35): 164–175. doi:10.14694/EdBook_AM.2015.35.164. PMID 25993154.
- ↑ Hallek M (November 2019). "Chronic lymphocytic leukemia: 2020 update on diagnosis, risk stratification and treatment". American Journal of Hematology. 94 (11): 1266–1287. doi:10.1002/ajh.25595. PMID 31364186. S2CID 199000131.
- ↑ Patel K, Pagel JM (April 2021). "Current and future treatment strategies in chronic lymphocytic leukemia". Journal of Hematology & Oncology. 14 (1): 69. doi:10.1186/s13045-021-01054-w. PMC 8074228. PMID 33902665.
- 1 2 3 4 Schetelig, Johannes; Dreger, Peter (2024), Sureda, Anna; Corbacioglu, Selim; Greco, Raffaella; Kröger, Nicolaus (eds.), "Chronic Lymphocytic Leukemia", The EBMT Handbook: Hematopoietic Cell Transplantation and Cellular Therapies (8th ed.), Cham (CH): Springer, ISBN 978-3-031-44079-3, PMID 39437068, retrieved 2025-01-22
- 1 2 3 4 Odetola, Oluwatobi; Ma, Shuo (October 2023). "Relapsed/Refractory Chronic Lymphocytic Leukemia (CLL)". Current Hematologic Malignancy Reports. 18 (5): 130–143. doi:10.1007/s11899-023-00700-z. ISSN 1558-822X. PMC 10242240. PMID 37278884.
- ↑ "Genes and Cancer". Archived from the original on 2021-11-16.
- 1 2 3 "Key Statistics for Chronic Lymphocytic Leukemia". www.cancer.org. Retrieved 2025-01-17.
- ↑ Grywalska E, Zaborek M, Łyczba J, Hrynkiewicz R, Bębnowska D, Becht R, et al. (November 2020). "Chronic Lymphocytic Leukemia-Induced Humoral Immunosuppression: A Systematic Review". Cells. 9 (11): 2398. doi:10.3390/cells9112398. PMC 7693361. PMID 33147729.
- 1 2 3 4 5 Gordon, Max J.; Ferrajoli, Alessandra (November 2022). "Unusual complications in the management of chronic lymphocytic leukemia". American Journal of Hematology. 97 (S2): S26 – S34. doi:10.1002/ajh.26585. ISSN 0361-8609. PMID 35491515.
- 1 2 3 4 Tadmor, Tamar; Levy, Ilana (2021-10-14). "Richter Transformation in Chronic Lymphocytic Leukemia: Update in the Era of Novel Agents". Cancers. 13 (20): 5141. doi:10.3390/cancers13205141. ISSN 2072-6694. PMC 8533993. PMID 34680290.
- 1 2 Sigmund AM, Kittai AS (August 2022). "Richter's Transformation". Current Oncology Reports. 24 (8): 1081–1090. doi:10.1007/s11912-022-01274-4. PMID 35384590. S2CID 247975378.
- ↑ D'Addona M, Giudice V, Pezzullo L, Ciancia G, Baldi C, Gorrese M, Bertolini A, Campana A, Fresolone L, Manzo P, Zeppa P, Serio B, Selleri C (August 2022). "Hodgkin Lymphoma and Hairy Cell Leukemia Arising from Chronic Lymphocytic Leukemia: Case Reports and Literature Review". Journal of Clinical Medicine. 11 (16): 4674. doi:10.3390/jcm11164674. PMC 9410146. PMID 36012912.
- ↑ Liu H, Miao Y, Ferrajoli A, Tang G, McDonnell T, Medeiros LJ, Hu S (March 2020). "Leukemic phase of Richter transformation: A mimic of acute myeloid leukemia that responded to Ibrutinib monotherapy". American Journal of Hematology. 95 (10): 1221–1223. doi:10.1002/ajh.25782. PMID 32162729. S2CID 212677249.
- ↑ Trimech M, Letourneau A, Missiaglia E, De Prijck B, Nagy-Hulliger M, Somja J, Vivario M, Gaulard P, Lambert F, Bisig B, de Leval L (June 2021). "Angioimmunoblastic T-Cell Lymphoma and Chronic Lymphocytic Leukemia/Small Lymphocytic Lymphoma: A Novel Form of Composite Lymphoma Potentially Mimicking Richter Syndrome". The American Journal of Surgical Pathology. 45 (6): 773–786. doi:10.1097/PAS.0000000000001646. hdl:2268/289883. PMID 33739791. S2CID 232301854.
- ↑ Travis LB, Curtis RE, Hankey BF, Fraumeni JF (September 1992). "Second cancers in patients with chronic lymphocytic leukemia". Journal of the National Cancer Institute. 84 (18): 1422–7. doi:10.1093/jnci/84.18.1422. PMID 1512794.
- ↑ Kumar V, Ailawadhi S, Bojanini L, Mehta A, Biswas S, Sher T, Roy V, Vishnu P, Marin-Acevedo J, Alegria VR, Paulus A, Aulakh S, Iqbal M, Manochakian R, Tan W, Chanan-Khan A, Ailawadhi M (September 2019). "Trends in the risk of second primary malignancies among survivors of chronic lymphocytic leukemia". Blood Cancer Journal. 9 (10): 75. doi:10.1038/s41408-019-0237-1. PMC 6768881. PMID 31570695.
- ↑ Soilleux EJ, Wotherspoon A, Eyre TA, Clifford R, Cabes M, Schuh AH (December 2016). "Diagnostic dilemmas of high-grade transformation (Richter's syndrome) of chronic lymphocytic leukaemia: results of the phase II National Cancer Research Institute CHOP-OR clinical trial specialist haemato-pathology central review". Histopathology. 69 (6): 1066–1076. doi:10.1111/his.13024. PMID 27345622. S2CID 205171057.
- ↑ Tsimberidou AM, Keating MJ (January 2005). "Richter syndrome: biology, incidence, and therapeutic strategies". Cancer. 103 (2): 216–228. doi:10.1002/cncr.20773. PMID 15578683. S2CID 21552054.
- ↑ Bitetto AM, Lamba G, Cadavid G, Shah D, Forlenza T, Rotatori F, Rafiyath SM. Colonic perforation secondary to chronic lymphocytic leukemia infiltration without Richter transformation. Leuk Lymphoma. 2011 May;52(5):930-3.
- 1 2 3 Strati P, Jain N, O'Brien S (May 2018). "Chronic Lymphocytic Leukemia: Diagnosis and Treatment". Mayo Clinic Proceedings (Review). 93 (5): 651–664. doi:10.1016/j.mayocp.2018.03.002. PMID 29728204.
- 1 2 3 4 5 6 7 Delgado J, Nadeu F, Colomer D, Campo E (September 2020). "Chronic lymphocytic leukemia: from molecular pathogenesis to novel therapeutic strategies". Haematologica. 105 (9): 2205–2217. doi:10.3324/haematol.2019.236000. PMC 7556519. PMID 33054046.
- ↑ Jarošová M, Plevová K, Kotašková J, Doubek M, Pospíšilová Š (October 2019). "The importance of complex karyotype in prognostication and treatment of chronic lymphocytic leukemia (CLL): a comprehensive review of the literature". Leukemia & Lymphoma. 60 (10): 2348–2355. doi:10.1080/10428194.2019.1576038. PMID 30773964. S2CID 73483725.
- ↑ Swerdlow SH (2017). WHO classification of tumours of haematopoietic and lymphoid tissues (Revised 4th ed.). Lyon: World Health Organization,, International Agency for Research on Cancer. p. 219. ISBN 978-92-832-4494-3. OCLC 1011064243.
- ↑ Sava GP, Speedy HE, Houlston RS (January 2014). "Candidate gene association studies and risk of chronic lymphocytic leukemia: a systematic review and meta-analysis". Leukemia & Lymphoma. 55 (1): 160–167. doi:10.3109/10428194.2013.800197. PMID 23647060. S2CID 207510537.
- ↑ Jaffe ES (January 2019). "Diagnosis and classification of lymphoma: Impact of technical advances". Seminars in Hematology. 56 (1): 30–36. doi:10.1053/j.seminhematol.2018.05.007. PMC 7394061. PMID 30573042.
- ↑ Angelillo P, Capasso A, Ghia P, Scarfò L (December 2018). "Monoclonal B-cell lymphocytosis: Does the elderly patient need a specialistic approach?". European Journal of Internal Medicine. 58: 2–6. doi:10.1016/j.ejim.2018.09.006. PMID 30268574. S2CID 52892403.
- ↑ Tresckow JV, Eichhorst B, Bahlo J, Hallek M (January 2019). "The Treatment of Chronic Lymphatic Leukemia". Deutsches Ärzteblatt International. 116 (4): 41–46. doi:10.3238/arztebl.2019.0041. PMC 6415618. PMID 30855005.
- ↑ Choi SM, O'Malley DP (December 2018). "Diagnostically relevant updates to the 2017 WHO classification of lymphoid neoplasms". Annals of Diagnostic Pathology. 37: 67–74. doi:10.1016/j.anndiagpath.2018.09.011. PMID 30308438. S2CID 52963674.
- 1 2 Hallek M (September 2017). "Chronic lymphocytic leukemia: 2017 update on diagnosis, risk stratification, and treatment". American Journal of Hematology. 92 (9): 946–965. doi:10.1002/ajh.24826. PMID 28782884.
- ↑ "Chronic Lymphocytic Leukemia". The Lecturio Medical Concept Library. Retrieved 9 July 2021.
- 1 2 Kreuzberger N, Damen JA, Trivella M, Estcourt LJ, Aldin A, Umlauff L, et al. (July 2020). "Prognostic models for newly-diagnosed chronic lymphocytic leukaemia in adults: a systematic review and meta-analysis". The Cochrane Database of Systematic Reviews. 2020 (7): CD012022. doi:10.1002/14651858.CD012022.pub2. PMC 8078230. PMID 32735048.
- ↑ Rai KR, Jain P (March 2016). "Chronic lymphocytic leukemia (CLL)-Then and now". American Journal of Hematology. 91 (3): 330–340. doi:10.1002/ajh.24282. PMID 26690614.
- 1 2 3 4 5 6 7 8 9 10 11 12 13 14 15 16 17 18 19 20 21 22 23 24 25 26 Hallek, Michael; Al-Sawaf, Othman (2021). "Chronic lymphocytic leukemia: 2022 update on diagnostic and therapeutic procedures". American Journal of Hematology. 96 (12): 1679–1705. doi:10.1002/ajh.26367. ISSN 1096-8652. PMID 34625994.
- 1 2 3 4 Woyach, Jennifer A.; Byrd, John C. (2022), Loscalzo, J; Fauci, Anthony S.; Kasper, Dennis L.; Hauser, Stephen L.; Longo, D; Jameson, J (eds.), "Chronic Lymphocytic Leukemia", Harrison's Principles of Internal Medicine (21 ed.), New York, NY: McGraw-Hill Education, retrieved 2023-01-29
- ↑ Binet JL, Auquier A, Dighiero G, Chastang C, Piguet H, Goasguen J, et al. (July 1981). "A new prognostic classification of chronic lymphocytic leukemia derived from a multivariate survival analysis". Cancer. 48 (1): 198–206. doi:10.1002/1097-0142(19810701)48:1<198::aid-cncr2820480131>3.0.co;2-v. PMID 7237385. S2CID 38619478.
- ↑ Lehmann S, Ogawa S, Raynaud SD, Sanada M, Nannya Y, Ticchioni M, et al. (March 2008). "Molecular allelokaryotyping of early-stage, untreated chronic lymphocytic leukemia". Cancer. 112 (6): 1296–1305. doi:10.1002/cncr.23270. PMID 18246537. S2CID 205651767.
- ↑ Sargent R, Jones D, Abruzzo LV, Yao H, Bonderover J, Cisneros M, et al. (January 2009). "Customized oligonucleotide array-based comparative genomic hybridization as a clinical assay for genomic profiling of chronic lymphocytic leukemia". The Journal of Molecular Diagnostics. 11 (1): 25–34. doi:10.2353/jmoldx.2009.080037. PMC 2607562. PMID 19074592.
- ↑ Schwaenen C, Nessling M, Wessendorf S, Salvi T, Wrobel G, Radlwimmer B, et al. (January 2004). "Automated array-based genomic profiling in chronic lymphocytic leukemia: development of a clinical tool and discovery of recurrent genomic alterations". Proceedings of the National Academy of Sciences of the United States of America. 101 (4): 1039–1044. Bibcode:2004PNAS..101.1039S. doi:10.1073/pnas.0304717101. PMC 327147. PMID 14730057.
- ↑ Pfeifer D, Pantic M, Skatulla I, Rawluk J, Kreutz C, Martens UM, et al. (February 2007). "Genome-wide analysis of DNA copy number changes and LOH in CLL using high-density SNP arrays". Blood. 109 (3): 1202–1210. doi:10.1182/blood-2006-07-034256. PMID 17053054.
- ↑ Gunn SR, Mohammed MS, Gorre ME, Cotter PD, Kim J, Bahler DW, et al. (September 2008). "Whole-genome scanning by array comparative genomic hybridization as a clinical tool for risk assessment in chronic lymphocytic leukemia". The Journal of Molecular Diagnostics. 10 (5): 442–451. doi:10.2353/jmoldx.2008.080033. PMC 2518739. PMID 18687794.
- 1 2 Didehban, Shiva; Jafari, Elham; Hosseini, Ali; Khorasani, Parisa (2024). "Evaluation of the Findings of Peripheral Blood Smear, Bone Marrow Aspiration and Biopsy, Iron Storage, and Immunophenotype in Patients with Chronic Lymphocytic Leukemia". Iranian Journal of Pathology. 19 (2): 152–159. doi:10.30699/IJP.2024.2011275.3170. ISSN 1735-5303. PMC 11304456. PMID 39118798.
- ↑ Cossarizza, Andrea; Chang, Hyun-Dong; Radbruch, Andreas; Abrignani, Sergio; Addo, Richard; Akdis, Mübeccel; Andrä, Immanuel; Andreata, Francesco; Annunziato, Francesco; Arranz, Eduardo; Bacher, Petra; Bari, Sudipto; Barnaba, Vincenzo; Barros-Martins, Joana; Baumjohann, Dirk (December 2021). "Guidelines for the use of flow cytometry and cell sorting in immunological studies (third edition)". European Journal of Immunology. 51 (12): 2708–3145. doi:10.1002/eji.202170126. ISSN 1521-4141. PMC 11115438. PMID 34910301.
- ↑ Bain, Barbara J. (2006). Blood Cells: A Practical Guide. Blackwell Publishing Limited. p. 439. ISBN 978-1-4051-4265-6.
- ↑ Greer JP, Arber DA, Glader B, List AF, Means Jr RT, Paraskevas F, Rodgers GM, Foerster J, eds. (2014). Wintrobe's clinical hematology (Thirteenth ed.). Lippincott Williams & Wilkins. ISBN 978-1451172683.
- ↑ Patteson AE, Carroll RJ, Iwamoto DV, Janmey PA (December 2020). "The vimentin cytoskeleton: when polymer physics meets cell biology". Physical Biology. 18 (1): 011001. doi:10.1088/1478-3975/abbcc2. PMC 8240483. PMID 32992303.
- ↑ Roepman, P.; Boots, C. M.; Scheidel, K. C.; Sprong, T.; De Bruin, P.; De Weerdt, O.; Groenen, P. J.; Kummer, J. A. (2016). "Molecular clonality assessment shows high performance to predict malignant B-cell non-Hodgkin's lymphoma using cytological smears". Journal of Clinical Pathology. 69 (12): 1109–1115. doi:10.1136/jclinpath-2016-203757. PMID 27169754. S2CID 30952923.
- ↑ Matutes E, Owusu-Ankomah K, Morilla R, Garcia Marco J, Houlihan A, Que TH, Catovsky D (October 1994). "The immunological profile of B-cell disorders and proposal of a scoring system for the diagnosis of CLL". Leukemia. 8 (10): 1640–1645. PMID 7523797.
- ↑ Deans JP, Polyak MJ (February 2008). "FMC7 is an epitope of CD20". Blood. 111 (4): 2492, author reply 2493-2492, author reply 2494. doi:10.1182/blood-2007-11-126243. PMID 18263793.
- ↑ Palumbo GA, Parrinello N, Fargione G, Cardillo K, Chiarenza A, Berretta S, et al. (September 2009). "CD200 expression may help in differential diagnosis between mantle cell lymphoma and B-cell chronic lymphocytic leukemia". Leukemia Research. 33 (9): 1212–1216. doi:10.1016/j.leukres.2009.01.017. PMID 19230971.
- ↑ Zare H, Bashashati A, Kridel R, Aghaeepour N, Haffari G, Connors JM, et al. (January 2012). "Automated analysis of multidimensional flow cytometry data improves diagnostic accuracy between mantle cell lymphoma and small lymphocytic lymphoma". American Journal of Clinical Pathology. 137 (1): 75–85. doi:10.1309/AJCPMMLQ67YOMGEW. PMC 4090220. PMID 22180480.
- ↑ "T Cell Prolymphocytic Leukemia". AccessMedicine. Archived from the original on 2011-07-07. Retrieved 2009-02-04.
- ↑ Ascani S, Leoni P, Fraternali Orcioni G, Bearzi I, Piccioli M, Materazzi M, et al. (June 1999). "T-cell prolymphocytic leukaemia: does the expression of CD8+ phenotype justify the identification of a new subtype? Description of two cases and review of the literature". Annals of Oncology. 10 (6): 649–653. doi:10.1023/A:1008349422735. PMID 10442186.
- ↑ Sud A, Dearden C (April 2017). "T-cell Prolymphocytic Leukemia". Hematology/Oncology Clinics of North America. 31 (2): 273–283. doi:10.1016/j.hoc.2016.11.010. PMID 28340878.
- ↑ Kasper, Dennis L.; Fauci, Anthony S.; Hauser, Stephen L.; Longo, Dan L.; Larry Jameson, J.; Loscalzo, Joseph (17 April 2015). "Malignancies of Lymphoid Cells". Harrison's Principles of Internal Medicine (19 ed.). McGraw Hill Professional. p. 695. ISBN 9780071802161.
- ↑ "France – Lymphoproliferative Syndrome B-Cell Prolymphocytic Leukemia |". icgc.org. Retrieved 2016-11-18.
- ↑ "Hairy Cell Leukemia". The Lecturio Medical Concept Library. Retrieved 24 July 2021.
- ↑ Langer-Safer PR, Levine M, Ward DC (July 1982). "Immunological method for mapping genes on Drosophila polytene chromosomes". Proceedings of the National Academy of Sciences of the United States of America. 79 (14): 4381–4385. Bibcode:1982PNAS...79.4381L. doi:10.1073/pnas.79.14.4381. PMC 346675. PMID 6812046.
- 1 2 3 "NCCN Guidelines for Chronic Lymphocytic Leukemia/Small Lymphocytic Lymphoma Version 1.2025". National Comprehensive Cancer Network. Retrieved 2025-01-22.
- ↑ Janssens; et al. (2011). "Rituximab for Chronic Lymphocytic Leukemia in Treatment-Naïve and Treatment-Experienced Patients". Contemporary Oncology. 3 (3): 24–36.
- 1 2 3 Hallek M, Cheson BD, Catovsky D, Caligaris-Cappio F, Dighiero G, Döhner H, et al. (June 2018). "iwCLL guidelines for diagnosis, indications for treatment, response assessment, and supportive management of CLL". Blood. 131 (25): 2745–2760. doi:10.1182/blood-2017-09-806398. PMID 29540348. S2CID 206956090.
- 1 2 Khan M, Siddiqi T (December 2018). "Targeted Therapies in CLL: Monotherapy Versus Combination Approaches". Current Hematologic Malignancy Reports. 13 (6): 525–533. doi:10.1007/s11899-018-0481-7. PMID 30535947. S2CID 54473182.
- ↑ Eichhorst BF, Busch R, Hopfinger G, Pasold R, Hensel M, Steinbrecher C, et al. (February 2006). "Fludarabine plus cyclophosphamide versus fludarabine alone in first-line therapy of younger patients with chronic lymphocytic leukemia". Blood. 107 (3): 885–891. doi:10.1182/blood-2005-06-2395. PMID 16219797.
- ↑ Byrd JC, Peterson BL, Morrison VA, Park K, Jacobson R, Hoke E, et al. (January 2003). "Randomized phase 2 study of fludarabine with concurrent versus sequential treatment with rituximab in symptomatic, untreated patients with B-cell chronic lymphocytic leukemia: results from Cancer and Leukemia Group B 9712 (CALGB 9712)". Blood. 101 (1): 6–14. doi:10.1182/blood-2002-04-1258. PMID 12393429.
- ↑ Keating MJ, O'Brien S, Albitar M, Lerner S, Plunkett W, Giles F, et al. (June 2005). "Early results of a chemoimmunotherapy regimen of fludarabine, cyclophosphamide, and rituximab as initial therapy for chronic lymphocytic leukemia". Journal of Clinical Oncology. 23 (18): 4079–4088. doi:10.1200/JCO.2005.12.051. PMID 15767648.
- ↑ Rai KR, Peterson BL, Appelbaum FR, Kolitz J, Elias L, Shepherd L, et al. (December 2000). "Fludarabine compared with chlorambucil as primary therapy for chronic lymphocytic leukemia". The New England Journal of Medicine. 343 (24): 1750–1757. doi:10.1056/NEJM200012143432402. PMID 11114313.
- ↑ Steurer M, Pall G, Richards S, Schwarzer G, Bohlius J, Greil R (July 2006). Steurer M (ed.). "Purine antagonists for chronic lymphocytic leukaemia". The Cochrane Database of Systematic Reviews. 3 (3): CD004270. doi:10.1002/14651858.CD004270.pub2. PMC 8407449. PMID 16856041.
- ↑ Hallek M, Fischer K, Fingerle-Rowson G, Fink AM, Busch R, Mayer J, et al. (October 2010). "Addition of rituximab to fludarabine and cyclophosphamide in patients with chronic lymphocytic leukaemia: a randomised, open-label, phase 3 trial". Lancet. 376 (9747): 1164–1174. doi:10.1016/S0140-6736(10)61381-5. PMID 20888994. S2CID 28834830.
- 1 2 3 4 Kaushansky K, Lichtman M, Beutler E, Kipps T, Prchal J, Seligsohn U (2010). Williams Hematology (8th ed.). McGraw-Hill. ISBN 978-0071621519.
- ↑ Gribben JG (January 2009). "Stem cell transplantation in chronic lymphocytic leukemia". Biology of Blood and Marrow Transplantation. 15 (1 Suppl): 53–58. doi:10.1016/j.bbmt.2008.10.022. PMC 2668540. PMID 19147079.
- ↑ Dreger P, Brand R, Hansz J, Milligan D, Corradini P, Finke J, et al. (May 2003). "Treatment-related mortality and graft-versus-leukemia activity after allogeneic stem cell transplantation for chronic lymphocytic leukemia using intensity-reduced conditioning". Leukemia. 17 (5): 841–848. doi:10.1038/sj.leu.2402905. PMID 12750695. S2CID 10144544.
- ↑ Molica S, Giannarelli D, Mirabelli R, Levato L, Shanafelt TD (July 2019). "The magnitude of improvement in progression-free survival with targeted therapy in relapsed/refractory chronic lymphocytic leukemia based on prognostic risk category: a systematic review and meta-analysis". Leukemia & Lymphoma. 60 (7): 1644–1649. doi:10.1080/10428194.2018.1543882. PMID 30516079. S2CID 54544330.
- ↑ Bosch F, Dalla-Favera R (November 2019). "Chronic lymphocytic leukaemia: from genetics to treatment". Nature Reviews. Clinical Oncology. 16 (11): 684–701. doi:10.1038/s41571-019-0239-8. PMID 31278397. S2CID 195804409.
- ↑ "Chronic Lymphocytic Leukemia – Cancer Stat Facts". SEER. Retrieved 2020-12-07.
- ↑ Rossi D, Lobetti Bodoni C, Genuardi E, Monitillo L, Drandi D, Cerri M, et al. (June 2009). "Telomere length is an independent predictor of survival, treatment requirement and Richter's syndrome transformation in chronic lymphocytic leukemia". Leukemia. 23 (6): 1062–1072. doi:10.1038/leu.2008.399. hdl:2434/663837. PMID 19340005.
- ↑ Al-Sawaf O, Robrecht S, Bahlo J, Fink AM, Cramer P, von Tresckow J, et al. (October 2017). "Impact of gender on outcome after chemoimmunotherapy in patients with chronic lymphocytic leukemia: a meta-analysis by the German CLL study group". Leukemia. 31 (10): 2251–2253. doi:10.1038/leu.2017.221. PMID 28745332. S2CID 6542508.
- 1 2 "Chronic lymphocytic leukaemia – Symptoms, diagnosis and treatment | BMJ Best Practice". bestpractice.bmj.com. Retrieved 2021-11-29.
- 1 2 Papadakis MA, McPhee SJ, Rabow MW, McQuaid KR (2022). Current medical diagnosis & treatment 2022 (Sixty-first ed.). [New York]. ISBN 9781264269389. OCLC 1264228575.
{{cite book}}: CS1 maint: location missing publisher (link) - 1 2 Jameson JL, Kasper DL, Longo DL, Fauci AS, Hauser SL, Loscalzo J (2018). Harrison's principles of internal medicine (20th ed.). New York. ISBN 978-1-259-64403-0. OCLC 1029074059.
{{cite book}}: CS1 maint: location missing publisher (link) - ↑ "Chronic lymphocytic leukaemia (CLL) statistics". Cancer Research UK. Retrieved 27 October 2014.
- ↑ Rawstron AC, Green MJ, Kuzmicki A, Kennedy B, Fenton JA, Evans PA, et al. (July 2002). "Monoclonal B lymphocytes with the characteristics of "indolent" chronic lymphocytic leukemia are present in 3.5% of adults with normal blood counts". Blood. 100 (2): 635–639. doi:10.1182/blood.V100.2.635. PMID 12091358.
- ↑ "Chronic Lymphocytic Leukemia". Cleveland Clinic. Retrieved 9 July 2021.
- ↑ Shanshal M, Haddad RY (April 2012). "Chronic lymphocytic leukemia". Disease-a-Month. 58 (4): 153–167. doi:10.1016/j.disamonth.2012.01.009. PMID 22449365.
- ↑ Turgeon ML (2005). Clinical hematology: theory and procedures. Hagerstown, MD: Lippincott Williams & Wilkins. p. 283. ISBN 978-0-7817-5007-3.
Frequency of lymphoid neoplasms. (Source: Modified from WHO Blue Book on Tumour of Hematopoietic and Lymphoid Tissues. 2001, p. 2001.)
- ↑ Boonhat H, Lin RT (December 2020). "Association between leukemia incidence and mortality and residential petrochemical exposure: A systematic review and meta-analysis". Environment International. 145: 106090. Bibcode:2020EnInt.14506090B. doi:10.1016/j.envint.2020.106090. PMID 32932064. S2CID 221748665.
- ↑ Pérez-Carretero C, González-Gascón-Y-Marín I, Rodríguez-Vicente AE, Quijada-Álamo M, Hernández-Rivas JÁ, Hernández-Sánchez M, Hernández-Rivas JM (May 2021). "The Evolving Landscape of Chronic Lymphocytic Leukemia on Diagnosis, Prognosis and Treatment". Diagnostics. 11 (5): 853. doi:10.3390/diagnostics11050853. PMC 8151186. PMID 34068813.
- ↑ Hampel, Paul J.; Parikh, Sameer A. (2022-11-29). "Chronic lymphocytic leukemia treatment algorithm 2022". Blood Cancer Journal. 12 (11): 161. doi:10.1038/s41408-022-00756-9. PMC 9708674. PMID 36446777.
- ↑ Kharfan-Dabaja MA, Kumar A, Hamadani M, Stilgenbauer S, Ghia P, Anasetti C, et al. (December 2016). "Clinical Practice Recommendations for Use of Allogeneic Hematopoietic Cell Transplantation in Chronic Lymphocytic Leukemia on Behalf of the Guidelines Committee of the American Society for Blood and Marrow Transplantation". Biology of Blood and Marrow Transplantation. 22 (12): 2117–2125. doi:10.1016/j.bbmt.2016.09.013. PMC 5116249. PMID 27660167.
- 1 2 Shapira T, Pereg D, Lishner M (September 2008). "How I treat acute and chronic leukemia in pregnancy". Blood Reviews. 22 (5): 247–259. doi:10.1016/j.blre.2008.03.006. PMID 18472198.